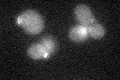
YPR188C
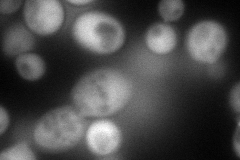
YPR188C
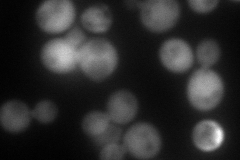
YPR188C
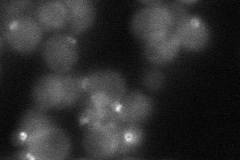
YPR188C
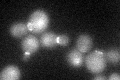
YPR188C
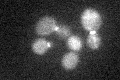
YPR188C

View description
Regulatory light chain for the type II myosin, Myo1p; binds to an IQ motif of Myo1p, localization to the bud neck depends on Myo1p; involved in the disassembly of the Myo1p ring
Localization:
Intensity:
Fold change:
Significance:
-
C’ GFP library in SD
bud neckN/A -
N' NOP1pr-GFP in SD
cytosol,bud neck150.641 -
N' TEF2pr-mCherry in SD
cytosol107.281 -
N' NATIVEpr-GFP in SD
bud neck32.9669 -
N' TEF2pr-VC and Cyto-VN in SD

#N/A0 -
C’ GFP library in SD+DTT
bud neck18.450.89No -
C’ GFP library in SD+H2O2
bud neck18.370.89No -
C’ GFP library in Starvation Media

cytosol20.160.97No -
C’ GFP library on the background of Pup2-DaMP

bud neck -
C’ GFP library on the background of CCT mutant

bud neck21.05871.02354No
